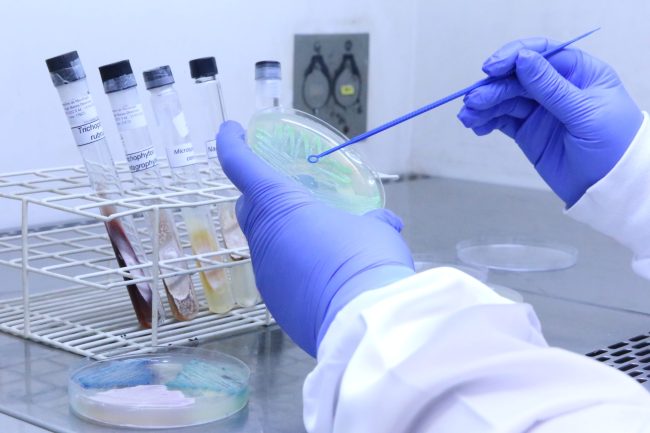

DIVULGAÇÃO DE DEFESA: Sheila Moura Pone
DIVULGAÇÃO DE DEFESA: Sheila Moura Pone Informamos que a defesa da Tese de Doutorado em Pesquisa Clínica em Doenças Infecciosas de Sheila Moura Pone, abaixo especificada, será realizada no dia 09 de fevereiro de 2015, no Auditório do Instituto Nacional de Infectologia Evandro Chagas, às 10 horas. Título da Tese: “Caracterização clínico-epidemiológica do dengue em…